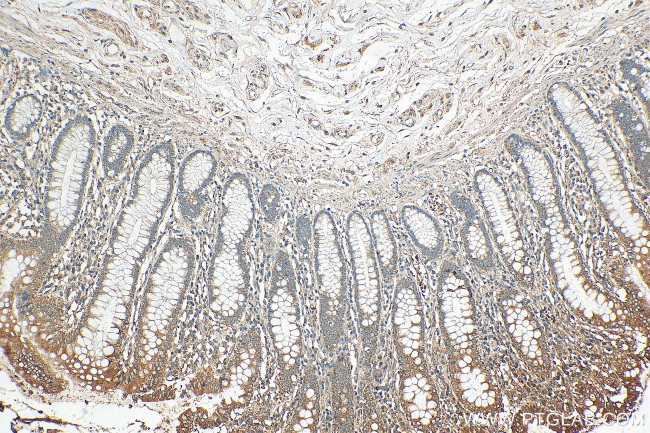
ERAL1 Antibody in Immunohistochemistry (Paraffin) (IHC (P))

Search
Proteintech
ERAL1 Polyclonal Antibody
{{$productOrderCtrl.translations['antibody.pdp.commerceCard.promotion.promotions']}}
{{$productOrderCtrl.translations['antibody.pdp.commerceCard.promotion.viewpromo']}}
{{$productOrderCtrl.translations['antibody.pdp.commerceCard.promotion.promocode']}}: {{promo.promoCode}} {{promo.promoTitle}} {{promo.promoDescription}}. {{$productOrderCtrl.translations['antibody.pdp.commerceCard.promotion.learnmore']}}
产品信息
29465-1-AP
种属反应
宿主/亚型
分类
类型
抗原
偶联物
形式
浓度
规格
纯化类型
保存液
内含物
保存条件
运输条件
产品详细信息
Aliquoting is unnecessary for -20°C storage.
靶标信息
The protein encoded by this gene is a GTPase that localizes to the mitochondrion. The encoded protein binds to the 3' terminal stem loop of 12S mitochondrial rRNA and is required for proper assembly of the 28S small mitochondrial ribosomal subunit. Deletion of this gene has been shown to cause mitochondrial dysfunction, growth retardation, and apoptosis. Several transcript variants encoding different isoforms have been found for this gene.
仅用于科研。不用于诊断过程。未经明确授权不得转售。
篇参考文献 (0)
生物信息学
蛋白别名: CEGA; Conserved ERA-like GTPase; era (E. coli G-protein homolog)-like 1; Era G-protein-like 1; ERA-like protein 1; ERA-W; GTP-binding protein era homolog; GTPase and RNA binding protein; GTPase Era, mitochondrial; GTPase, human homolog of E. coli essential cell cycle protein Era; H-ERA; unnamed protein product
基因别名: CEGA; ERA; ERA-W; ERAL1; ERAL1A; ERAL1B; H-ERA; HERA; HERA-A; HERA-B; PRLTS6
UniProt ID: (Human) O75616
Entrez Gene ID: (Human) 26284